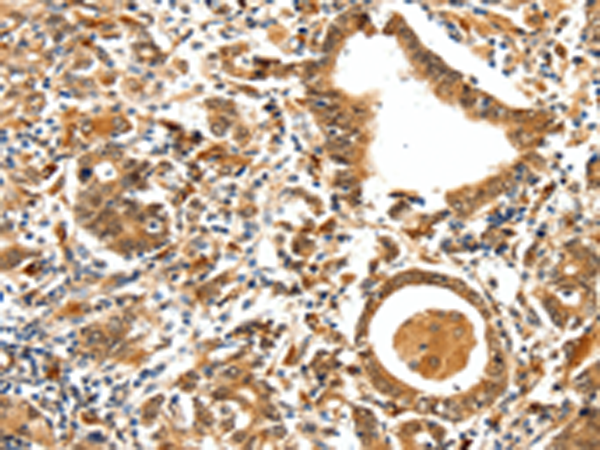
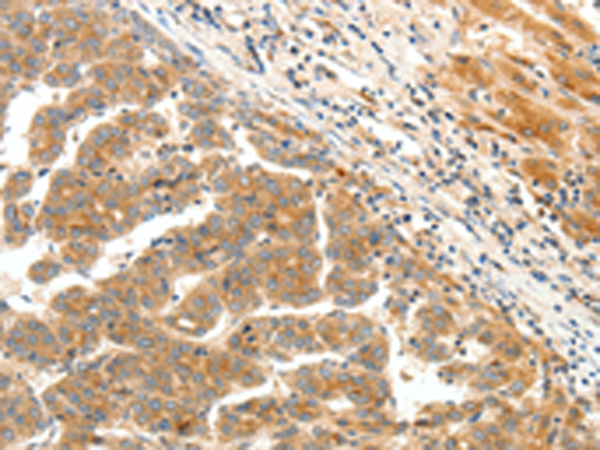

-
分类: 科研抗体货号: P11124别名: NAP4; NCKAP4应用: IHC反应种属: Human, Mouse
-
分类: 科研抗体货号: P11143别名: BCH, BHC, NK-2, TEBP, TTF1, NKX2A, TITF1, TTF-1, NKX2.1应用: WB反应种属: Human, Mouse, Rat
-
分类: 科研抗体货号: P11154别名: DOP1; DOPEY1; KIAA1117; dJ202D23.2应用: IHC反应种属: Human, Mouse
-
分类: 科研抗体货号: P11142别名: DA1, DA2B, NEM4, TMSB, AMCD1应用: WB,IHC反应种属: Human, Mouse, Rat
-
分类: 科研抗体货号: P11153别名: LPA5; GPR92; GPR93; KPG_010应用: IHC反应种属: Human
-
分类: 科研抗体货号: P11141别名: MTC; TRK; TRK1; TRKA; Trk-A; p140-TrkA应用: IHC反应种属: Human, Mouse, Rat
-
分类: 科研抗体货号: P11150别名: VPF; VEGF; MVCD1应用: WB,IHC反应种属: Human
-
分类: 科研抗体货号: P11140别名: TRF2; TRBF2应用: IHC反应种属: Human
-
分类: 科研抗体货号: P11149别名: UI; UROC应用: IHC反应种属: Human, Mouse, Rat
-
分类: 科研抗体货号: P11173别名: BSCL; BSCL1; LPAAB; 1-AGPAT2; LPAAT-beta应用: WB,IHC反应种属: Human

鄂公网安备42018502007531号
鄂公网安备42018502007531号

